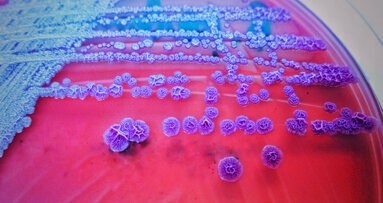
New summary of antimicrobial prescription guidelines available

LEIPZIG, Germany: As any postoperative infection can potentially be linked to the oral cavity, researchers have evaluated the oral health, oral health knowledge and oral hygiene behaviours of patients in Germany scheduled for placement of endoprostheses (EP) to determine whether such patients receive adequate education on oral health and EP. Orthopaedic surgeons were also consulted about patient oral health and dental care in relation to EP. The findings suggest that a lack of interdisciplinary care is responsible for subpar patient oral hygiene behaviours and education.
The researchers, from the University of Leipzig and the University of Leipzig Medical Center, consulted EP patients prior to their procedures using a questionnaire to evaluate their oral hygiene behaviours and knowledge on oral health and the relationship between oral health and EP and to note any pre-existing oral health problems. They found that only 35.5% of the patients felt informed of the connection between oral health and EP. Only 25% had even informed their dentists about their planned EP procedure. Although 62.8% reported feeling educated about oral health overall, only half received regular professional tooth cleaning and 29.1% stated that they performed interdental cleaning, indicating extensive deficits in oral hygiene behaviours.
Only 14% of the orthopaedic surgeons reported contact with dentists, but there was little indication on whether any effort was made to consult dentists regarding evaluation and screening for oral health concerns prior to EP procedures. This is despite 92.8% of the surgeons reporting awareness of the relationship between EP infections and oral health.
The researchers also noted that, although current literature no longer recommends antibiotic prophylaxis prior to dental intervention, 76.0% of the orthopaedic surgeons surveyed recommended it, despite only 7.2% having knowledge of the recommended prophylactic drugs and dosages. The surgeons surveyed indicated that a standardised risk classification system for EP patients and guidelines on dental care prior to or after EP placement were important.
The survey results showed that the orthopaedic surgeons had little to no collaboration with dental care providers. The researchers thus suggested that the surgeons establish a pattern of preoperative dental referrals as an alternative to broad recommendations of antibiotic prophylaxis. They also suggested that there were systemic issues at play in that the separate education of dentists and physicians in Germany that appear to have resulted in significant knowledge gaps and divergent expectations that should be addressed at the level of undergraduate and postgraduate education regarding other medical fields.
The study, titled “Lack of oral health awareness and interdisciplinary dental care: A survey in patients prior to endoprosthesis and orthopaedic centres in Germany”, was published on 13 February 2023 in BMC Oral Health.
Tags:
GOTHENBURG, Sweden: The University of Gothenburg has announced further investment into an already robust research programme on antibiotic resistance. The ...
LONDON, UK: To help dental teams play their part in tackling the problem of antimicrobial resistance, the College of General Dentistry and Faculty of Dental...
The digital revolution continues. Like all areas of dentistry, implantology is going digital. The potential benefits of a digital workflow can be applied to...
Live webinar
Thu. 2 July 2026
11:00 am EST (New York)
Dr. Albéric Santamaria-Loisy
Live webinar
Thu. 2 July 2026
2:00 pm EST (New York)
Live webinar
Mon. 6 July 2026
12:00 pm EST (New York)
Live webinar
Tue. 7 July 2026
8:00 pm EST (New York)
Dr. Mark Donaldson BSP, ACPR, PHARMD, FASHP, FACHE
Live webinar
Wed. 8 July 2026
8:00 am EST (New York)
Live webinar
Wed. 8 July 2026
1:00 pm EST (New York)
Prof. Gianluca Gambarini MD, DDS
Live webinar
Wed. 8 July 2026
10:00 pm EST (New York)
Dr. Jae Seon Kim DDS, MSD, FACP, CDT



 Austria / Österreich
Austria / Österreich
 Bosnia and Herzegovina / Босна и Херцеговина
Bosnia and Herzegovina / Босна и Херцеговина
 Bulgaria / България
Bulgaria / България
 Croatia / Hrvatska
Croatia / Hrvatska
 Czech Republic & Slovakia / Česká republika & Slovensko
Czech Republic & Slovakia / Česká republika & Slovensko
 France / France
France / France
 Germany / Deutschland
Germany / Deutschland
 Greece / ΕΛΛΑΔΑ
Greece / ΕΛΛΑΔΑ
 Hungary / Hungary
Hungary / Hungary
 Italy / Italia
Italy / Italia
 Netherlands / Nederland
Netherlands / Nederland
 Nordic / Nordic
Nordic / Nordic
 Poland / Polska
Poland / Polska
 Portugal / Portugal
Portugal / Portugal
 Romania & Moldova / România & Moldova
Romania & Moldova / România & Moldova
 Slovenia / Slovenija
Slovenia / Slovenija
 Serbia & Montenegro / Србија и Црна Гора
Serbia & Montenegro / Србија и Црна Гора
 Spain / España
Spain / España
 Switzerland / Schweiz
Switzerland / Schweiz
 Turkey / Türkiye
Turkey / Türkiye
 UK & Ireland / UK & Ireland
UK & Ireland / UK & Ireland
 Brazil / Brasil
Brazil / Brasil
 Canada / Canada
Canada / Canada
 Latin America / Latinoamérica
Latin America / Latinoamérica
 USA / USA
USA / USA
 China / 中国
China / 中国
 India / भारत गणराज्य
India / भारत गणराज्य
 Pakistan / Pākistān
Pakistan / Pākistān
 Vietnam / Việt Nam
Vietnam / Việt Nam
 ASEAN / ASEAN
ASEAN / ASEAN
 Israel / מְדִינַת יִשְׂרָאֵל
Israel / מְדִינַת יִשְׂרָאֵל
 Algeria, Morocco & Tunisia / الجزائر والمغرب وتونس
Algeria, Morocco & Tunisia / الجزائر والمغرب وتونس
 Middle East / Middle East
Middle East / Middle East

To post a reply please login or register